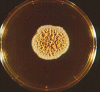
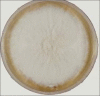

A clinical and mycological study of dermatophytic infections
- PMID: 24891657
- PMCID: PMC4037947
- DOI: 10.4103/0019-5154.131391
A clinical and mycological study of dermatophytic infections
Abstract
Background: Dermatophytoses refer to superficial fungal infection of keratinized tissues caused by keratinophilic dermatophytes. According to observations worldwide, dermatophytoses are the most common of the superficial fungal infections. It is common in tropics and may present in epidemic proportions in areas with high rates of humidity. Although common, the precise size of the problem defies measurement.
Aims: The present study was undertaken to assess the clinical profile of dermatophytic infection and to identify the species of fungi that are prevalent in this region.
Materials and methods: A total of 100 patients clinically suspected for dermatophytoses were selected for the study. Direct microscopy in 10% potassium hydroxide (KOH) and culture was done in each case.
Results: Out of 100 patients, the maximum were seen in the age groups of 16-30 years. Tinea corporis was the most common clinical type (44.3%) followed by tinea cruris (38.2%). Overall positivity by culture was 39% and by direct microscopy 96%.
Conclusion: Trichophyton rubrum was the predominant species isolated (67.5%) in all clinical types followed by Trichophyton mentagrophytes. Culturing the fungus may identify the species, but it is not essential for the diagnosis as it is not a sensitive test.
Keywords: Dermatophytosis; dermatophyte; tinea; trichophyton.
Conflict of interest statement
Figures

References
-
- Gorbach SL, Bartlett JL, Blacklow NR. 3rd ed. Philadelphia: Lippincott Williams and Wilkins; 2004. Infectious disease; pp. 1162–80.
-
- Kanwar AJ, Mamta, Chander J. Superficial fungal infections. In: Valia GR, editor. IADVL Text book and Atlas of Dermatology. 2nd ed. Mumbai: Bhalani Publishing House; 2001. pp. 215–58.
-
- Bindu V, Pavithran K. Clinico-Mycological study of dermatophytosis in Calicut. Indian J Dermatol Venereol Leprol. 2002;68:259–61. - PubMed
-
- Peerapur BV, Inamdar AC, Pushpa PV, Srikant B. Clinico Mycological Study of Dermatophytosis in Bijapur. Indian J Dermatol Venerol Leprol. 2004;22:273–74. - PubMed
-
- Singh S, Beena PM. Profile of Dermatophyte infection in Baroda. Indian J Dermatol Venerol Leprol. 2003;69:281–3. - PubMed
LinkOut - more resources
Full Text Sources
Other Literature Sources
